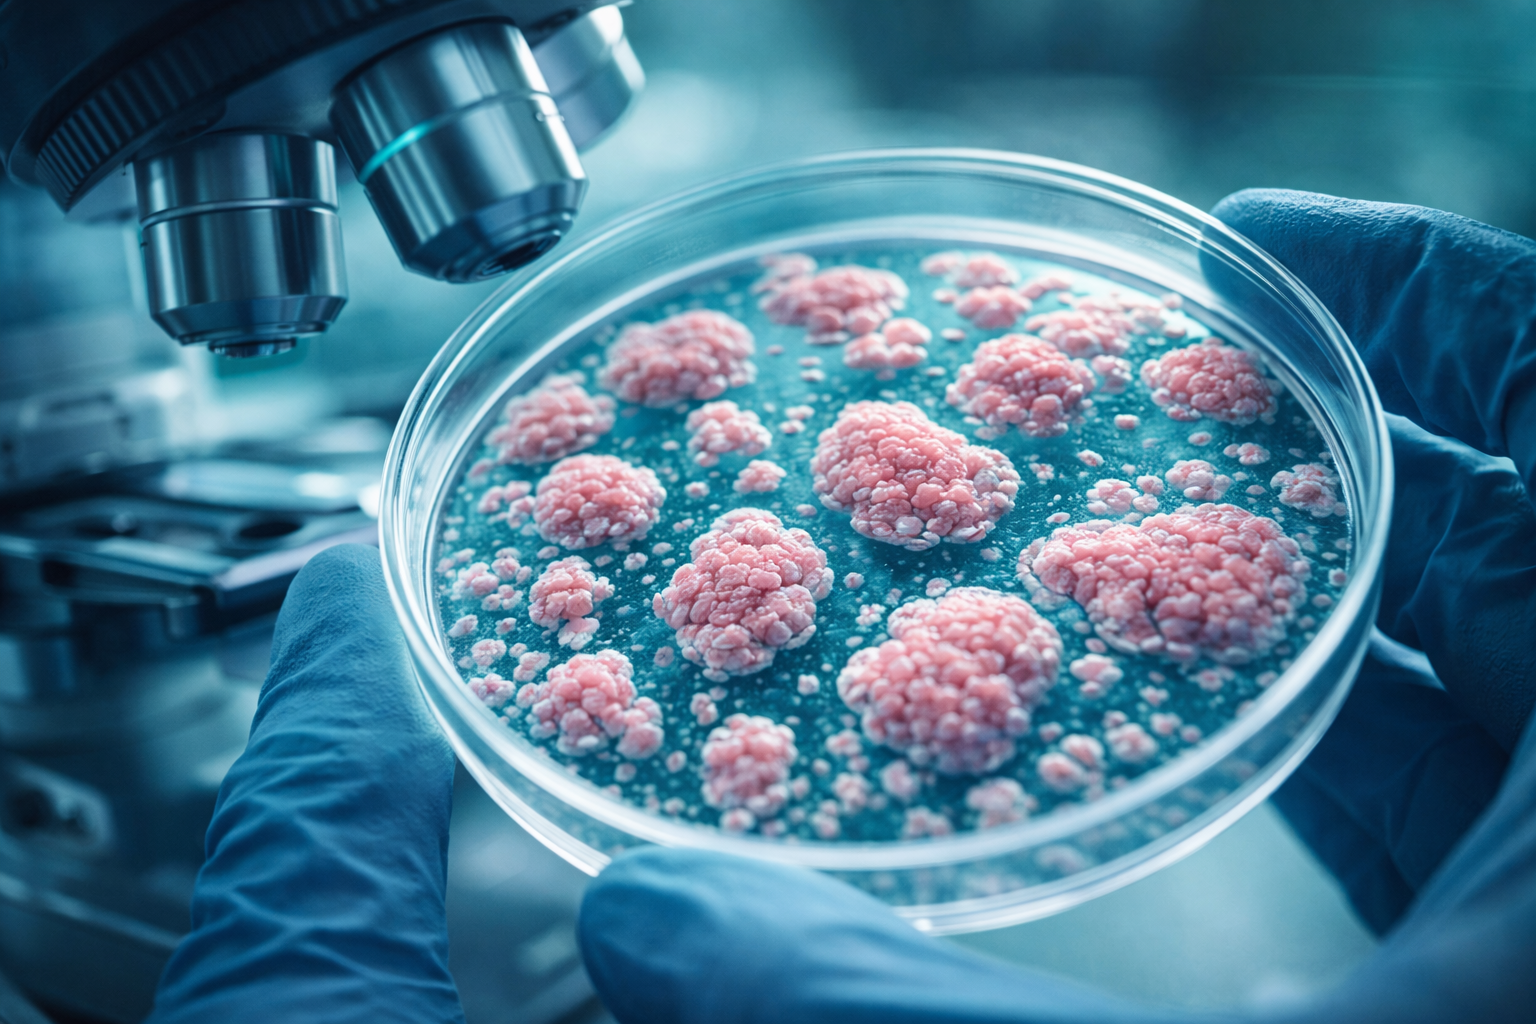
Study flags allergy shifts in cultivated beef

IN Brief:
- Cultured bovine cells showed fewer traditional protein allergens than steak in tests.
- Alpha-gal-associated responses were stronger in a small number of blood samples.
- Researchers plan follow-on work on finished cultivated meat products.
A peer-reviewed study has reported a mixed allergy hazard profile for cultivated beef cells when compared with conventional steak, finding reduced levels of several traditional beef allergen proteins but stronger immune reactivity in samples linked to alpha-gal sensitivity. The work adds a new layer of food safety scrutiny for cultivated meat developers as the sector moves from pilot production towards broader commercial timelines.
The research, published in the Journal of Agricultural and Food Chemistry, compared the protein composition and allergenic potential of cultured beef cells with standard beef steak. The team cultured male cow muscle cells for varying periods using established protocols, then assessed how the cultured material differed from conventional meat at the protein level and in immunological testing.
Across the cultured samples, the researchers found broadly consistent protein compositions despite different culture times, but with clear differences versus steak. Most identified allergenic proteins were present at similar or lower levels in the cultured cells compared with conventional beef, with the exception of three proteins that are not classified as major meat allergens by the World Health Organization, but can react with immunoglobulin E (IgE) and provoke immune responses in some people.
To probe functional allergenicity, the researchers tested blood samples from a small group of meat-allergic individuals. In those experiments, IgE binding to both undigested and digested cultured cells was generally lower than binding to conventional beef, aligning with the reduced levels of typical allergen-related proteins. However, the pattern changed for alpha-gal-associated responses: cultured cells triggered strong IgE reactivity in two blood samples from individuals with alpha-gal sensitivity. The researchers suggested the effect could be linked to higher levels of alpha-gal-modified proteins in the cultivated cells.
Renwick Dobson, corresponding author of the research, said, “Our results show why food safety assessments for cultivated meat need to look carefully at allergy-related proteins.” The team has indicated that a next step is to extend testing beyond cultured cell material to finished cultivated meat products, where additional ingredients, processing steps, and structural formation could further shift the allergen profile.
The study also included a disclosure that some authors were co-founders, employees, or shareholders in Opo Bio Aotearoa, the biotechnology company that supplied the cell culture used in the work. That disclosure sits alongside the study’s central implication for product development: cultivated meat cannot be assumed to mirror conventional meat allergen behaviour purely because both originate from the same species.
As regulatory dossiers for novel proteins continue to expand in depth, the results are likely to sharpen expectations around allergen characterisation. Developers pursuing cultivated beef will need to demonstrate not only microbial safety and compositional consistency, but also how the product behaves against known allergy mechanisms, including alpha-gal, which does not map cleanly onto traditional protein allergen frameworks.